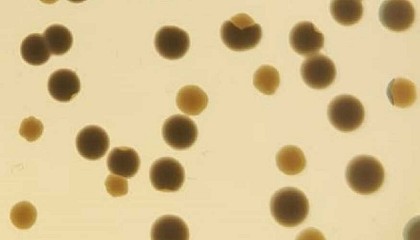

Resultados de la búsqueda "mecanismo"
Pall-X 96 Power marca nuevos estándares en barnices monocomponentes - 18/07/2025

mecánica de un barniz de 2 componentes con la facilidad de uso de un producto monocomponente. Redacción Interempresas Mientras que las excelentes propiedades de fluidez aseguran un resultado uniforme, la denominada
Asefave reclama una fiscalidad más favorable para impulsar la rehabilitación y la eficiencia energética en España - 25/06/2025

mecanismos actuales de incentivación de la rehabilitación y la eficiencia energética en edificios y viviendas, especialmente tras la, en general, mala experiencia de los Fondos Next Generation. Redacción Interempresas Pese
Una serie multitáctil avanzada y de coste optimizado, diseñada para conceptos operativos altamente eficientes - 08/05/2025

mecánica, esta plataforma de dispositivos mantiene y refuerza su ventaja tecnológica de cara al futuro. De este modo, la calidad consistentemente alta de los paneles de control y monitores industriales
Entrevista a Michael Fuller, presidente de Conflux Technology - 17/02/2026

mecánica y cumplimiento de los exigentes requisitos de certificación aeronáutica? Los materiales avanzados, como la aleación de aluminio CP1 y el acero inoxidable 316L, pueden ofrecer una combinación útil de capacidad
Modelec incorpora la domótica a sus mecanismos - 15/10/2024

mecanismos - 15/10/2024: La marca también ha incorporado el sistema de domótica semi integrado en tres colecciones: Fascination, Confidence y M. Modelec incorpora la domótica a sus mecanismos Modelec , la firma
Retos y oportunidades para la industria y para el mercado de las máquinas usadas en 2024 - 17/12/2024

mecánica y el sector automotriz. Mientras el retroceso en la producción y los ajustes estructurales hicieron evidentes las dificultades, el mercado de la maquinaria usada supuso una alternativa flexible y económica
El Ayuntamiento de Vitoria Gasteiz invertirá 1,7 millones de euros en tres años para el correcto funcionamiento de las escaleras mecánicas - 09/12/2024

mecánicas - 09/12/2024: El Ayuntamiento de Vitoria Gasteiz invertirá 1,7 millones de euros en tres años para el correcto funcionamiento de las escaleras mecánicas Sale a contratación el servicio de puesta
Saint-Gobain Isover presenta Climliner Roll G1: La solución para aislar conductos metálicos por el interior - 03/11/2025

mecánica y sostenibilidad. Este producto, diseñado para instalaciones de climatización y ventilación, incorpora mejoras como mayor optimización de metros cuadrados por palet, embalaje sostenible y un nuevo tejido de vidrio
Machos de dureza variable: beneficios y simulaciones numéricas - 16/04/2025

Mecánica no lineal y modelos de materiales El know-how de UFS incluye el uso de mecánica no lineal para simular condiciones extremas y modelos avanzados de materiales para predecir
Nueva generación Sila de Lancor: el futuro del gearless - 21/06/2025

mecánica y la fiabilidad operativa marcan la diferencia, Lancor Motores Eléctricos , vuelve a posicionarse a la vanguardia con una evolución innovativa del producto. Tras más de 80 años de experiencia
Zoller cumple 80 años de precisión, innovación y visión de futuro - 15/07/2025

mecánico fundado por Alfred Zoller en Ludwigsburg, en la región alemana de Baden-Wurtemberg, se ha convertido en un proveedor de sistemas con presencia global. Con pasión y visión, tres
La innovación, el cumplimiento normativo y la sostenibilidad: elementos fundamentales de la experiencia A+A de Ansell - 04/11/2025

mecánicos y de salas blancas. Con más de un millón de trabajadores que mueren cada año en todo el mundo por exposición a productos químicos peligrosos, el mayor evento mundial
Zeatz busca técnico de diseño en fabricación mecánica - 15/11/2024

mecánica - 15/11/2024: Zeatz busca técnico de diseño en fabricación mecánica La empresa Zeatz , especializada en el sector de la máquina-herramienta y CNC, destacada por ofrecer soluciones avanzadas en diseño
Mecanismos de seguridad en los aviones ante fenómenos meteorológicos adversos - 16/01/2025

Mecanismos de seguridad en los aviones ante fenómenos meteorológicos adversos - 16/01/2025: Para evitar espacios donde se está produciendo un fenómeno adverso, los aviones detectan y mapean las condiciones meteorológicas en la ruta
Fimic presenta el filtro FCS para una limpieza completa de los rascadores - 18/02/2026

mecánico encargado de limpiar de forma rápida y forzada los canales del rascador. A diferencia de las soluciones tradicionales, este sistema no depende de la presión de entrada, lo que permite
Puertas para grandes huecos: cuando la calidad del sistema marca la diferencia - 19/01/2026

mecánico estable incluso en condiciones exigentes de carga, viento y uso intensivo. Esta certificación ofrece al instalador una seguridad real al trabajar con sistemas cuyo rendimiento ha sido validado y que están
La mandrinadora portátil Elsa reduce las paradas innecesarias en el sector petrolero - 13/01/2026

mecánicas y entornos extremos. En este contexto, cada hora de inactividad de la planta tiene un impacto económico significativo y cada error técnico puede convertirse en un problema de seguridad
Descubren un mecanismo que acelera la evolución de bacterias resistentes a los antibióticos - 16/09/2024
mecanismo que acelera la evolución de bacterias resistentes a los antibióticos - 16/09/2024: Descubren un mecanismo que acelera la evolución de bacterias resistentes a los antibióticos Colonias de la bacteria Klebsiella
Nuevo sensor de vibración Ifm VVB3: Anticipa, actúa y ahorra - 16/05/2025

mecánicos antes de que afecten al proceso productivo. Redacción Interempresas Una de las técnicas más efectivas es la medición de vibraciones en componentes clave como motores, bombas o ventiladores. Detectar
¿En qué consiste el mecanismo de ajuste en frontera por carbono y por qué es tan polémico? - 21/03/2024

mecanismo, el 1 de enero de 2026, los importadores estarán obligados a comprar los certificados CBAM correspondientes. Cabe señalar que este mecanismo no es un impuesto a liquidar a la importación
